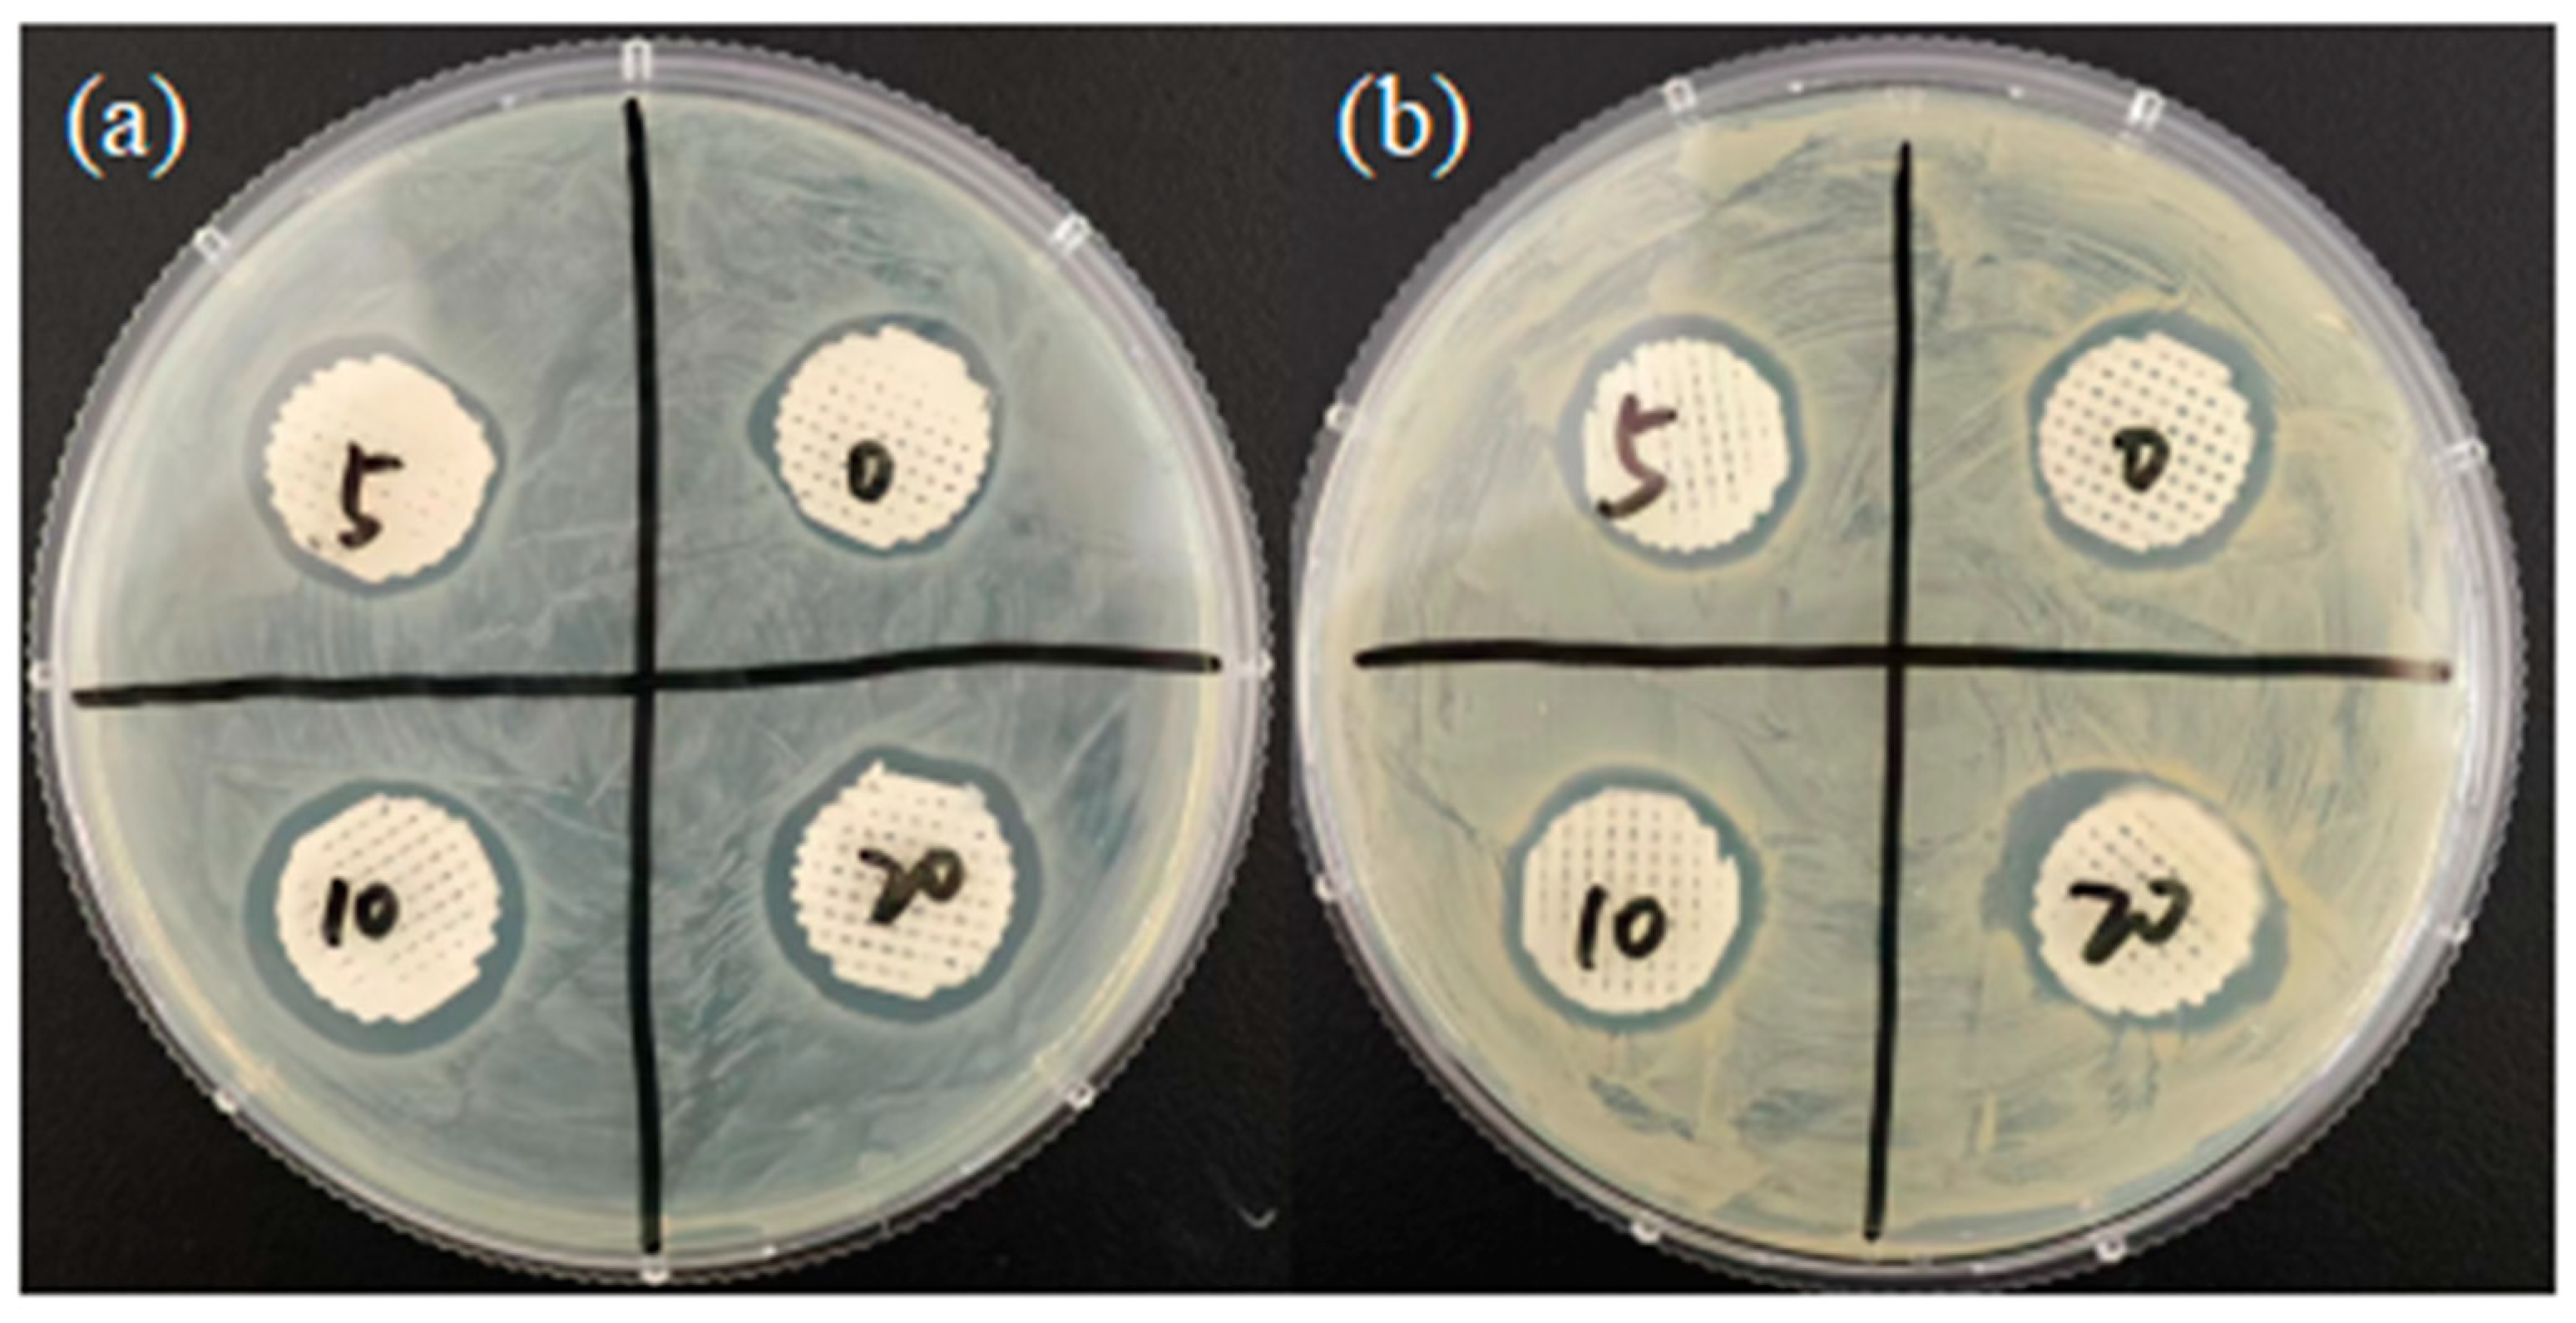
Polymers 16 03379 g009

Antibacterial Properties of PCL@45s5 Composite Biomaterial Scaffolds Based on Additive Manufacturing
Abstract
1. Introduction
2. Materials and Methods
2.1. Fabrication of 3D-Printed PCL, PCL/45s5 Scaffolds
2.2. Macroscopic Observation of the Scaffolds
2.3. Microscopic Morphology of 45s5 Powder
2.4. XRD Analysis
2.5. Melt Flow Rate
2.6. Heating Rheological Test
2.7. Differential Scanning Calorimetry (DSC)
2.8. Contact Angle
2.9. Modulus of Elasticity
2.10. In Vitro Degradation Rate
2.11. Antibacterial Test
2.11.1. Preparation of Medium
2.11.2. Antibacterial Circle Test
2.11.3. Gram Staining Test
3. Results
3.1. Morphology Observations
3.2. X-Ray Diffraction (XRD) Analysis
3.3. Melt Flow Rate of Composite Materials
3.4. DSC Result of Composite Materials
3.5. Contact Angles
3.6. The Result of Rheology
3.7. Modulus of Elasticity
3.8. In Vitro Biodegradation of Composite Scaffolds
3.9. Antibacterial Experiment
4. Results and Discussion
Author Contributions
Funding
Institutional Review Board Statement
Data Availability Statement
Acknowledgments
Conflicts of Interest
References
- Wubneh, A.; Tsekoura, E.K.; Ayranci, C.; Uludag, H. Current state of fabrication technologies and materials for bone tissue engineering. Acta Biomater. 2018, 80, 1–30. [Google Scholar] [CrossRef] [PubMed]
- Zheng, C.; Zhang, M.M. 3D-printed PCL/β-TCP/CS composite artificial bone and histocompatibility study. J. Orthop. Surg. Res. 2023, 18, 1–9. [Google Scholar] [CrossRef]
- Alzhavan, O.; Ghaderi, E.; Shahsavar, M. Graphene nanogrids for selective and fast osteogenic differentiation of human mesenchymal stem cells. Carbon 2013, 59, 200–211. [Google Scholar] [CrossRef]
- Yang, L.; Liu, Y.X.; Sun, L.Y.; Zhao, C.; Chen, G.P.; Zhao, Y.J. Biomass Microcapsules with Stem Cell Encapsulation for Bone Repair. Nano-Micro Lett. 2022, 14, 1–12. [Google Scholar] [CrossRef] [PubMed]
- Robinson, P.G.; Abrams, G.D.; Sherman, S.L.; Safran, M.R.; Murray, I.R. Autologous Bone Grafting. Oper. Tech. Sports Med. 2020, 28, 150780. [Google Scholar] [CrossRef]
- Pape, H.C.; Evans, A.; Kobbe, P. Autologous Bone Graft: Properties and Techniques. J. Orthop. Trauma 2010, 24, S36–S40. [Google Scholar] [CrossRef]
- Ahmed, G.A.; Ishaque, B.; Rickert, M.; Fölsch, C. Allogeneic bone transplantation in hip revision surgery. Indications and potential for reconstruction. Orthopade 2018, 47, 52–66. [Google Scholar] [CrossRef]
- Betz, R.R. Limitations of autograft and allograft: New synthetic solutions. Orthopedics 2002, 25, S561–S570. [Google Scholar] [CrossRef]
- Velásquez-García, L.F.; Kornbluth, Y. Biomedical Applications of Metal 3D Printing. In Annual Review of Biomedical Engineering; Yarmush, M.L., Ed.; Annual Review of Biomedical Engineering: Palo Alto, CA, USA, 2021; Volume 23, pp. 307–338. [Google Scholar]
- Hanawa, T. Biocompatibility of titanium from the viewpoint of its surface. Sci. Technol. Adv. Mater. 2022, 23, 457–472. [Google Scholar] [CrossRef]
- Yaghmoori, K.; Kerayechian, N.; Azizi, A.; Ghahremani, N.; Rezvan, F.; Amiri, A. Evaluation of flexural strength of denture-based materials reinforced with AL2O3, SIO2, TIO2, and ZRO2 nanoparticles: A systematic review and meta-analysis. Gomal J. Med. Sci. 2023, 21, 184–196. [Google Scholar] [CrossRef]
- Miao, L.; Gao, M.; Chen, S.Y.; Wang, J.H.; Zhang, H.F.; Tan, L.L.; Pan, Y.P. The mechanical properties and bioactivity of Ti-Mg composites as orthopedic implants: A pilot study. J. Mater. Res. Technol. 2024, 28, 1074–1083. [Google Scholar] [CrossRef]
- Akhavan, O.; Ghaderi, E. Capping antibacterial Ag nanorods aligned on Ti interlayer by mesoporous TiO2 layer. Surf. Coat. Technol. 2009, 203, 3123–3128. [Google Scholar] [CrossRef]
- Seddiki, O.; Harnagea, C.; Levesque, L.; Mantovani, D.; Rosei, F. Evidence of antibacterial activity on titanium surfaces through nanotextures. Appl. Surf. Sci. 2014, 308, 275–284. [Google Scholar] [CrossRef]
- Costa, B.C.; Tokuhara, C.K.; Rocha, L.A.; Oliveira, R.C.; Lisboa, P.N.; Pessoa, J.C. Vanadium ionic species from degradation of Ti-6Al-4V metallic implants: In vitro cytotoxicity and speciation evaluation. Mater. Sci. Eng. C-Mater. Biol. Appl. 2019, 96, 730–739. [Google Scholar] [CrossRef]
- Zhang, C.; Chen, S.H.; Vigneshwaran, M.; Qi, Y.; Zhou, Y.L.; Fu, G.S.; Li, Z.Y.; Wang, J.L. Effect of Different Contents of 63s Bioglass on the Performance of Bioglass-PCL Composite Bone Scaffolds. Inventions 2023, 8, 138. [Google Scholar] [CrossRef]
- Emadi, H.; Karevan, M.; Rad, M.M.; Sadeghzade, S.; Pahlevanzadeh, F.; Khodaei, M.; Khayatzadeh, S.; Lotfian, S. Bioactive and Biodegradable Polycaprolactone-Based Nanocomposite for Bone Repair Applications. Polymers 2023, 15, 3617. [Google Scholar] [CrossRef]
- Hedayati, S.K.; Behravesh, A.H.; Hasannia, S.; Saed, A.B.; Akhoundi, B. 3D printed PCL scaffold reinforced with continuous biodegradable fiber yarn: A study on mechanical and cell viability properties. Polym. Test. 2020, 83, 106347. [Google Scholar] [CrossRef]
- Hajiali, F.; Tajbakhsh, S.; Shojaei, A. Fabrication and Properties of Polycaprolactone Composites Containing Calcium Phosphate-Based Ceramics and Bioactive Glasses in Bone Tissue Engineering: A Review. Polym. Rev. 2018, 58, 164–207. [Google Scholar] [CrossRef]
- Ebrahimi, Z.; Irani, S.; Ardeshirylajimi, A.; Seyedjafari, E. Enhanced osteogenic differentiation of stem cells by 3D printed PCL scaffolds coated with collagen and hydroxyapatite. Sci. Rep. 2022, 12, 12359. [Google Scholar] [CrossRef]
- Eqtesadi, S.; Motealleh, A.; Pajares, A.; Guiberteau, F.; Miranda, P. Influence of sintering temperature on the mechanical properties of ε-PCL-impregnated 45S5 bioglass-derived scaffolds fabricated by robocasting. J. Eur. Ceram. Soc. 2015, 35, 3985–3993. [Google Scholar] [CrossRef]
- Daskalakis, E.; Huang, B.Y.; Vyas, C.; Acar, A.A.; Fallah, A.; Cooper, G.; Weightman, A.; Koc, B.; Blunn, G.; Bartolo, P. Novel 3D Bioglass Scaffolds for Bone Tissue Regeneration. Polymers 2022, 14, 445. [Google Scholar] [CrossRef] [PubMed]
- Kolan, K.C.R.; Li, J.; Roberts, S.; Semon, J.A.; Park, J.; Day, D.E.; Leu, M.C. Near-field electrospinning of a polymer/bioactive glass composite to fabricate 3D biomimetic structures. Int. J. Bioprinting 2019, 5, 163. [Google Scholar] [CrossRef]
- Cho, Y.S.; Choi, S.; Lee, S.H.; Kim, K.K.; Cho, Y.S. Assessments of polycaprolactone/hydroxyapatite composite scaffold with enhanced biomimetic mineralization by exposure to hydroxyapatite via a 3D-printing system and alkaline erosion. Eur. Polym. J. 2019, 113, 340–348. [Google Scholar] [CrossRef]
- LeGeros, R.Z. Calcium phosphate materials in restorative dentistry: A review. Adv. Dent. Res. 1988, 2, 164–180. [Google Scholar] [CrossRef] [PubMed]
- Hu, S.; Chang, J.; Liu, M.Q.; Ning, C.Q. Study on antibacterial effect of 45S5 Bioglass®. J. Mater. Sci.-Mater. Med. 2009, 20, 281–286. [Google Scholar] [CrossRef] [PubMed]
- Mazaheri, M.; Akhavan, O.; Simchi, A. Flexible bactericidal graphene oxide-chitosan layers for stem cell proliferation. Appl. Surf. Sci. 2014, 301, 456–462. [Google Scholar] [CrossRef]
- Rahighi, R.; Panahi, M.; Akhavan, O.; Mansoorianfar, M. Pressure-engineered electrophoretic deposition for gentamicin loading within osteoblast-specific cellulose nanofiber scaffolds. Mater. Chem. Phys. 2021, 272, 125018. [Google Scholar] [CrossRef]
- Zhao, Y.C.; Wang, Z.; Zhao, J.Z.; Hussain, M.; Wang, M.N. Additive Manufacturing in Orthopedics: A Review. Acs Biomater. Sci. Eng. 2022, 8, 1367–1380. [Google Scholar] [CrossRef]
- Wei, S.A.; Ma, J.X.; Xu, L.; Gu, X.S.; Ma, X.L. Biodegradable materials for bone defect repair. Mil. Med. Res. 2020, 7, 54. [Google Scholar] [CrossRef]
- Nyiranzeyimana, G.; Mutua, J.M.; Mose, B.R.; Mbuya, T.O. Optimization of process parameters in fused deposition modelling of thermoplastics: A reviewOptimierung der Prozessparameter bei der Modellierung des Schmelz-Auftragschweissens von Thermoplasten: Ein uberblick. Mater. Werkst. 2021, 52, 682–694. [Google Scholar] [CrossRef]
- Chen, G.Q.; Shu, X.; Liu, J.P.; Zhang, B.G.; Feng, J.C. A new coating method with potential for additive manufacturing: Premelting electron beam-assisted freeform fabrication. Addit. Manuf. 2020, 33, 101118. [Google Scholar] [CrossRef]
- Goetzendorfer, B.; Mohr, T.; Hellmann, R. Hybrid Approaches for Selective Laser Sintering by Building on Dissimilar Materials. Materials 2020, 13, 5285. [Google Scholar] [CrossRef] [PubMed]
- Huang, J.G.; Qin, Q.; Wang, J. A Review of Stereolithography: Processes and Systems. Processes 2020, 8, 1138. [Google Scholar] [CrossRef]
- Zhao, Y.C.; Hou, Y.; Li, Z.Y.; Wang, Z.Y.; Yan, X.X. Powder-Based 3D Printed Porous Structure and Its Application as Bone Scaffold. Front. Mater. 2020, 7, 150. [Google Scholar] [CrossRef]
- Semitela, A.; Girao, A.F.; Fernandes, C.; Ramalho, G.; Bdikin, I.; Completo, A.; Marques, P. Electrospinning of bioactive polycaprolactone-gelatin nanofibres with increased pore size for cartilage tissue engineering applications. J. Biomater. Appl. 2020, 35, 471–484. [Google Scholar] [CrossRef] [PubMed]
- Liu, R.X.; Ma, L.L.; Liu, H.; Xu, B.H.; Feng, C.W.; He, R.J. Effects of pore size on the mechanical and biological properties of stereolithographic 3D printed HAp bioceramic scaffold. Ceram. Int. 2021, 47, 28924–28931. [Google Scholar] [CrossRef]
- Gebler, M.; Uiterkamp, A.J.M.S.; Visser, C. A global sustainability perspective on 3D printing technologies. Energy Policy 2014, 74, 158–167. [Google Scholar] [CrossRef]
- Ventola, C.L. Medical Applications for 3D Printing: Current and Projected Uses. Pharm. Ther. 2014, 39, 704–711. [Google Scholar]
- Tavakoli, Z.; Ansari, M.; Poursamar, S.A.; Rafienia, M.; Eslami, H.; Zare, F.; Shirani, S.; Alizadeh, M.H. Synergetic effect of bioglass and nano montmorillonite on 3D printed nanocomposite of polycaprolactone/gelatin in the fabrication of bone scaffolds. Int. J. Biol. Macromol. 2024, 281, 136384. [Google Scholar] [CrossRef]
- Wang, C.L.; Meng, C.Y.; Zhang, Z.; Zhu, Q.S. 3D printing of polycaprolactone/bioactive glass composite scaffolds for in situ bone repair. Ceram. Int. 2022, 48, 7491–7499. [Google Scholar] [CrossRef]
- Balu, R.; Kumar, T.S.S.; Ramalingam, M.; Ramakrishna, S. Electrospun Polycaprolactone/Poly(1,4-butylene adipate-co-polycaprolactam) Blends: Potential Biodegradable Scaffold for Bone Tissue Regeneration. J. Biomater. Tissue Eng. 2011, 1, 30–39. [Google Scholar] [CrossRef]
- Daskalakis, E.; Hassan, M.H.; Omar, A.M.; Cooper, G.; Weightman, A.; Bartolo, P. Rheological behaviour of different composite materials for additive manufacturing of 3D bone scaffolds. J. Mater. Res. Technol. 2023, 24, 3670–3682. [Google Scholar] [CrossRef]

| 1 | 2 | 3 | Average | σ | ||
|---|---|---|---|---|---|---|
| PCL | Weight (g) | 0.47 | 0.47 | 0.46 | 0.47 | 0.0058 |
| Diameter (mm) | 14.92 | 15.24 | 14.98 | 15.05 | 0.1701 | |
| Height (mm) | 4.20 | 4.06 | 4.14 | 4.13 | 0.0702 | |
| PCL/45s5 5 wt% | Weight (g) | 0.44 | 0.46 | 0.47 | 0.46 | 0.0153 |
| Diameter (mm) | 15.16 | 15.62 | 15.36 | 15.38 | 0.2307 | |
| Height (mm) | 3.98 | 3.86 | 4.04 | 3.96 | 0.0917 | |
| PCL/45s5 10 wt% | Weight (g) | 0.47 | 0.43 | 0.48 | 0.46 | 0.0265 |
| Diameter (mm) | 15.78 | 14.98 | 15.52 | 15.43 | 0.4081 | |
| Height (mm) | 4.26 | 4.08 | 4.06 | 4.13 | 0.1102 | |
| PCL/45s5 20 wt% | Weight (g) | 0.39 | 0.45 | 0.41 | 0.42 | 0.0306 |
| Diameter (mm) | 15.20 | 15.74 | 15.36 | 15.43 | 0.2774 | |
| Height (mm) | 4.28 | 4.08 | 4.12 | 4.16 | 0.1058 | |
| 1 | 2 | 3 | Average | σ | |
|---|---|---|---|---|---|
| PCL | 94.30 | 93.30 | 94.50 | 94.03 | 0.64 |
| PCL/45s5 5 wt% | 73.00 | 73.20 | 71.40 | 75.53 | 0.99 |
| PCL/45s5 10 wt% | 66.60 | 67.00 | 67.30 | 66.97 | 0.35 |
| PCL/45s5 20 wt% | 60.00 | 60.00 | 58.10 | 59.37 | 1.10 |
| Before | After | Difference | |
|---|---|---|---|
| PCL | 0.4698 g | 0.4680 g | 0.0018 g |
| PCL/45s5 5 wt% | 0.4472 g | 0.4446 g | 0.0026 g |
| PCL/45s5 10 wt% | 0.4754 g | 0.4687 g | 0.0067 g |
| PCL/45s5 20 wt% | 0.3980 g | 0.3834 g | 0.0146 g |
| Escherichia coli | Staphylococcus aureus | |||||||
|---|---|---|---|---|---|---|---|---|
| PCL | 5 wt% 45s5 | 10 wt% 45s5 | 20 wt% 45s5 | PCL | 5 wt% 45s5 | 10 wt% 45s5 | 20 wt% 45s5 | |
| Parallel 1 (cm) | 1.95 | 1.92 | 1.99 | 1.98 | 1.81 | 1.82 | 1.90 | 2.35 |
| 1.82 | 1.90 | 1.91 | 1.97 | 1.90 | 1.85 | 1.95 | 1.85 | |
| 1.90 | 1.91 | 1.98 | 1.95 | 1.86 | 1.88 | 1.97 | 1.90 | |
| Parallel 2 (cm) | 1.82 | 1.87 | 2.08 | 2.09 | 1.70 | 1.90 | 1.95 | 1.98 |
| 1.81 | 1.90 | 2.00 | 2.02 | 1.80 | 1.85 | 1.90 | 1.90 | |
| 1.88 | 1.85 | 2.02 | 2.01 | 1.82 | 1.80 | 1.88 | 1.91 | |
| Parallel 3 (cm) | 1.91 | 1.85 | 1.92 | 1.91 | 1.86 | 1.90 | 1.90 | 1.97 |
| 1.93 | 1.90 | 1.90 | 1.90 | 1.80 | 1.91 | 1.95 | 1.91 | |
| 1.90 | 1.82 | 1.95 | 1.91 | 1.85 | 1.92 | 1.90 | 1.90 | |
| Average (cm) | 1.88 | 1.88 | 1.97 | 1.97 | 1.82 | 1.87 | 1.92 | 1.96 |
Disclaimer/Publisher’s Note: The statements, opinions and data contained in all publications are solely those of the individual author(s) and contributor(s) and not of MDPI and/or the editor(s). MDPI and/or the editor(s) disclaim responsibility for any injury to people or property resulting from any ideas, methods, instructions or products referred to in the content. |
© 2024 by the authors. Licensee MDPI, Basel, Switzerland. This article is an open access article distributed under the terms and conditions of the Creative Commons Attribution (CC BY) license (https://creativecommons.org/licenses/by/4.0/).
Share and Cite
Zhang, C.; Ru, Y.; You, J.; Lin, R.; Chen, S.; Qi, Y.; Li, D.; Zhang, C.; Qiu, Z. Antibacterial Properties of PCL@45s5 Composite Biomaterial Scaffolds Based on Additive Manufacturing. Polymers 2024, 16, 3379. https://doi.org/10.3390/polym16233379
Zhang C, Ru Y, You J, Lin R, Chen S, Qi Y, Li D, Zhang C, Qiu Z. Antibacterial Properties of PCL@45s5 Composite Biomaterial Scaffolds Based on Additive Manufacturing. Polymers. 2024; 16(23):3379. https://doi.org/10.3390/polym16233379
Chicago/Turabian StyleZhang, Chen, Yixian Ru, Jinchao You, Runyi Lin, Shihao Chen, Yi Qi, Dejing Li, Cheng Zhang, and Zhenli Qiu. 2024. "Antibacterial Properties of PCL@45s5 Composite Biomaterial Scaffolds Based on Additive Manufacturing" Polymers 16, no. 23: 3379. https://doi.org/10.3390/polym16233379
APA StyleZhang, C., Ru, Y., You, J., Lin, R., Chen, S., Qi, Y., Li, D., Zhang, C., & Qiu, Z. (2024). Antibacterial Properties of PCL@45s5 Composite Biomaterial Scaffolds Based on Additive Manufacturing. Polymers, 16(23), 3379. https://doi.org/10.3390/polym16233379

